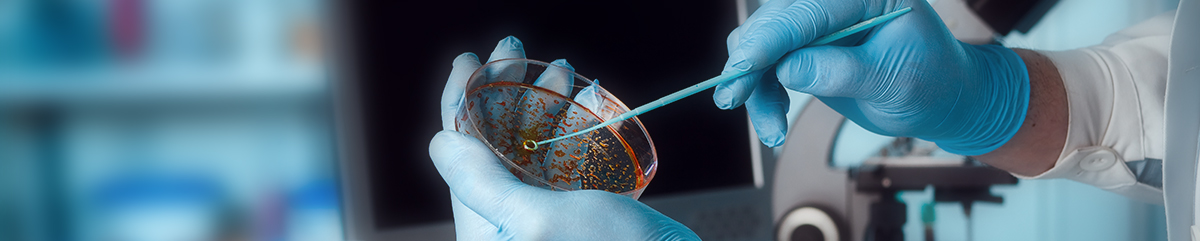

| Parameter | Butyl Rubber | Test Method |
|---|---|---|
| Mooney Viscosity ML1+8 @ 125 Deg C | 46-56 | |
| Unsaturation Level. Mole % | 1.4-1.8 | Internal Method |
| Calcium stearate content , % Max | 1.2 | Internal Method |
| Volatile Content, % Max | 0.3 | ASTM D 5668 |
| Non-standing Antioxidant content, % | 0.02-0.08 | Internal Method |
| Ash Content, % Max | 0.4 | ASTM D 5667 |